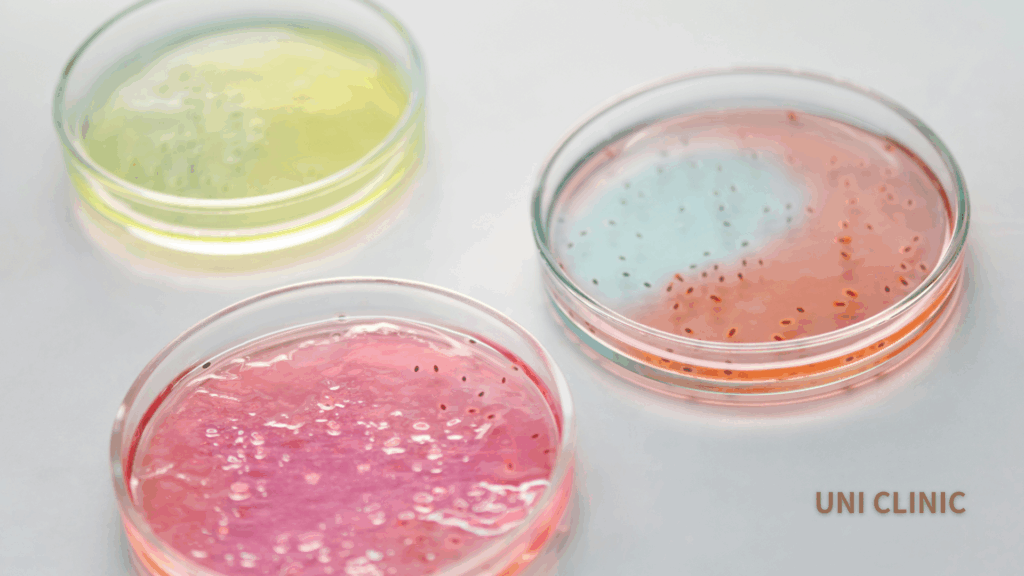

【美容内科×美容皮膚科コンビネーションを用いて、本来の美しさのポテンシャルを引き出す】
大阪・北堀江の UNI CLINIC (ユニクリニック) 院長、大嶋です。
私たちは 美容皮膚科と美容内科 の両面からアプローチし、外側だけでなく、体の内側から本質的な美しさを引き出す治療を提供しています。
特に、分子栄養学を活かした美容内科アプローチ により、肌の健康を根本から支えることを大切にしています。
お一人おひとりの悩みに寄り添い、美容皮膚科施術と美容内科のバランスを丁寧にカウンセリングしながら、最適な治療プランをご提案させていただきます。
はじめに

「保湿も変えた、外用も工夫した。でも肌荒れがぶり返す」──。
そんな患者様の背景に、“腸内真菌(Candida albicans)” の増えすぎ=腸内ディスバイオシスが関与していることがあります。外側だけでなく、腸から整える視点も必要になります。今回は肌荒れにも関与する、カンジダ菌についてお話します。
1.カンジダとは?
カンジダは腸・口腔・皮膚・膣などに常在する酵母様真菌で、耳なじみがあるのは性器感染ではないでしょうか。しかし、カンジダは前述のとおり様々な臓器に存在します。特に腸内に存在するカンジダの量が肌荒れにも関わっています。普段は日和見菌として存在しますが、暴飲暴食、抗生剤使用、糖質過多な食事、ストレス、睡眠不足、ホルモン変動などで過増殖しやすくなると考えられています。腸内での真菌バランスの乱れ(mycobiome dysbiosis)は、腸粘膜の透過性上昇(リーキーガット)と慢性炎症を誘発し、皮膚症状にも波及します※1。
2.カンジダと肌荒れの関係

カンジダと肌荒れは深く関わっています。カンジダの過増殖により腸炎が悪化し、腸漏出と炎症性サイトカイン上昇が確認され、※1、真菌叢の変化は皮膚バリアやアトピー性皮膚炎、酒さなどの炎症に関与することもわかっています※2。また、腸粘膜バリアの破綻(タイトジャンクションの異常)は全身性炎症と皮膚免疫に影響すると考えられています※3。このように腸管粘膜やバリア機能の維持、ケアが、肌管理にも大事であることがわかります。
3.増えすぎの背景

ではどうすればカンジダが増えてしまうのでしょうか。
代表的なものとして、砂糖・精製炭水化物の摂取、アルコール、抗生剤・ピルの長期使用、睡眠不足、ストレス、口腔衛生不良・便通異常などが挙げられます。特にカンジダ菌は甘いものや糖質が好きなので、それらを頻繁に摂取すると、カンジダ菌は暴走してしまいます。
カンジダ菌の暴走→腸粘膜のバリア破綻→リーキーガット症候群→肌荒れ、という流れ、何となく覚えてきましたよね。やはり口から入れるものの意識が重要です。
4.カンジダと腸活

ここまでくると、腸内環境が大切であることはわっかてきましたね。腸内環境を整えるために、「菌を足す」よりも「善玉菌が働きやすい土壌を作る」ほうが、カンジダ対策としても理にかなっていると考えます。ここでは “プレバイオティクス” 、”短鎖脂肪酸(SCFA)”について述べます。
▶ プレバイオティクスとは
イヌリン、フルクトオリゴ糖、ガラクトオリゴ糖、レジスタントスターチなど、善玉菌の“餌”として機能する食物繊維。これらは腸内で発酵され、”短鎖脂肪酸(SCFA)”を生みだします。
※食物繊維については過去コラムも参照ください
▶ SCFAとカンジダの関係
SCFA(酢酸・プロピオン酸・酪酸)は カンジダの成長・菌糸形成・バイオフィルム形成を抑制します※4、一方で抗生剤投与にて SCFA が減少すると カンジダ定着が増加するというデータもあります※5。また、酪酸は腸上皮のタイトジャンクションを強化し、炎症を鎮めることで腸漏れ→皮膚炎症の連鎖を断つことができます※6。
つまり、プレバイオティクスによってSCFAを増やすことで、カンジダ抑制的環境を作れる可能性が示唆されます。いわゆる腸活も大事になりますね。
5.オーソモレキュラー的アプローチ

当院で実践しているものを少しご紹介します。
A. 腸内環境リセット
プレバイオティクス食:野菜・豆類・海藻・未精製穀物を増やす。
プロバイオティクス補助:乳酸菌のサプリメントなど品質確かな製剤を短期使用したり、和食中心の発酵食品からの摂取を推奨。
糖質制限:精製糖・アルコールを控え、カンジダの餌を減らす。
B. 栄養素サポート
ビオチン・ナイアシン:脂質代謝・皮膚バリアに寄与。
亜鉛・Mg・B群:皮膚ターンオーバー・免疫調節に必須。
食物繊維・ビタミンD:腸粘膜の保護。
C. 点滴療法(補助的位置づけ)
ビタミンC、グルタチオンは酸化ストレス抑制・肝サポート目的。
カンジダ直接抑制ではなく、“再発しにくい代謝状態”の補助に。
一つでも実践できそうなものがあれば積極的に生活に取り入れてくださいね。また、カンジダの活動性は遅延型フードアレルギー検査で調べる事ができます。※遅延型フードアレルギー検査については過去コラムご参照ください。
まとめ
スキンケアで改善しない肌荒れの一部には、腸内カンジダの影響が隠れている可能性があります。プレバイオティクスでSCFA産生を促すことが、真菌増殖を抑える鍵にもなります。もちろんその他の腸にいい栄養素も超重要です。栄養・腸・皮膚を一体で見る“オーソモレキュラー的腸活”が、肌トラブルの根本改善につながると考えています。ご興味のある方はぜひ一度ご来院ください。
参考文献
※1:Panpetch B. et al., Sci Rep. 2019;9:7324.
※2:Nguyen LN et al., Front Cell Infect Microbiol. 2022.
※3:Camilleri M., Gastroenterology. 2019;157:403–420.
※4:Noverr MC et al., Infect Immun. 2001;69(11):6821–6832.
※5:Zhang H et al., Sci Rep. 2019;9:45467.
※6:Koh A et al., Nat Rev Gastroenterol Hepatol. 2016;13(10):661–678.